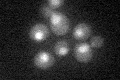
YBR195C
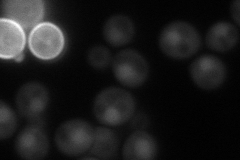
YBR195C
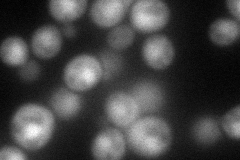
YBR195C
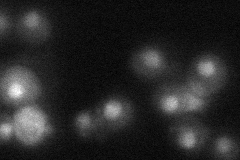
YBR195C
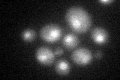
YBR195C
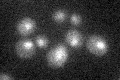
YBR195C

View description
Subunit of chromatin assembly factor I (CAF-1), negative regulator of the RAS/cAMP pathway via sequestration of Npr1p kinase; localizes to the nucleus and cytoplasm; homologous to human retinoblastoma binding proteins RbAp48 and RbAp46
Localization:
Intensity:
Fold change:
Significance:
-
C’ GFP library in SD
nucleus24.56 -
N' NOP1pr-GFP in SD
cytosol,nucleus68.4131 -
N' TEF2pr-mCherry in SD
nucleus74.9128 -
N' NATIVEpr-GFP in SD
nucleus30.0373 -
N' TEF2pr-VC and Cyto-VN in SD

#N/A0 -
C’ GFP library in SD+DTT
nucleus22.050.89No -
C’ GFP library in SD+H2O2

nucleus22.510.91No -
C’ GFP library in Starvation Media
nucleus20.460.83No -
C’ GFP library on the background of Pup2-DaMP

nucleus -
C’ GFP library on the background of CCT mutant

nucleus24.02020.977861No
